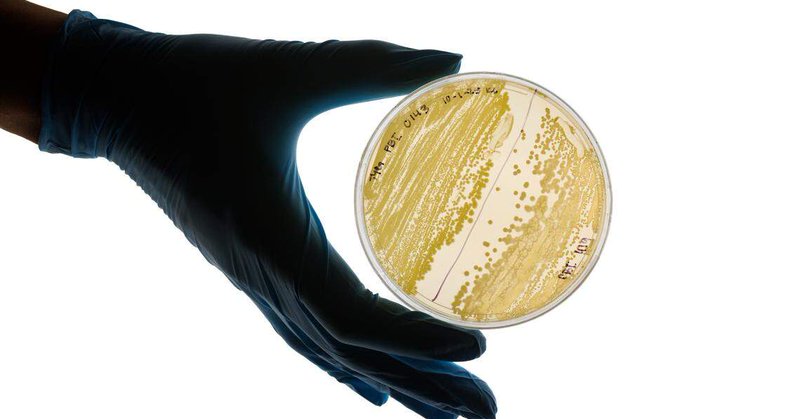
Tweet card summary image

Cal Poly Bailey College of Science and Mathematics
@CalPolyCSM
Followers
1K
Following
2K
Media
1K
Statuses
3K
Where science, mathematics, the art of teaching and California's Central Coast intersect. California Polytechnic State University. #LearnByDoing
San Luis Obispo, CA
Joined July 2015
We’re excited to celebrate seven incredible startups that have officially completed the CIE Incubator program! 🎉 These founders spent two years building their startups, and we couldn’t be prouder of their progress. Read about graduating companies here: https://t.co/ygXNNguVLi
1
1
2
Are you ready to take your startup to new heights? Applications for AngelCon are open! 👏 This is your chance to secure $100K+ in equity investment and propel your startup to the next level. 💰 Learn more and apply today: https://t.co/pP4Ldhv0Qs
0
1
0
A fellowship program is supporting faculty from across the California State University system to improve teacher preparation for serving multilingual students. A Cal Poly assistant professor is among the first cohort. Story link:
calstate.edu
The CSU's new Early Childhood Multilingual Literacy Teacher Preparation Faculty Fellowship will focus on improving the university’s teacher preparation programs to better equip future teachers for...
0
1
1
Cal Poly students study ancient bacteria stuck in amber. ‘Jurassic Park vibes’
sanluisobispo.com
A 93-specimen collection was donated by professor emeritus Raul Cano, who once worked with the scientist who inspired Michael Crichton’s iconic sci-fi novel.
1
1
1
When you give today, you help our students learn by doing — and thrive while doing it! On #GivingTuesday2025, join us in supporting Bailey College programs that elevate student success. 💛📚 Give Now Here: https://t.co/8tur5fvJ35
@CalPoly @CalPolyAlumni #GivingTuesday
0
0
0
⏰ It all starts today — and ends tonight! The Cal Poly application for Fall 2026 closes soon. Apply now and get ready to turn your goals into action. Learn more today at https://t.co/KOtNNlygTX
0
2
4
Unfortunately, this Saturday's planned Cal Poly Pier Open House (Nov. 15) has been canceled due to rain. Stay tuned for next year's event!
0
0
0
Cal Poly is hiring! We are looking for multiple tenure-track colleagues, including animal physiology, cell biology, and microbiology! Please spread the word. https://t.co/mIVhfNECgW Links in thread.
1
4
10
The Cal Poly Women's Mobile Health Unit does impactful work to support uninsured community members on the Central Coast and to help address gaps in health care that might otherwise go unmet. Help support the program in the link below! @CalPoly Link: https://t.co/j3blIjOWmI
0
0
1
Cal Poly tree enthusiasts set out in search of the largest Sierra juniper tree on Earth. Here's what they found:
calpoly.edu
0
0
0
Gameday! Mustangs open the 2025-26 season at USC! Tip time 6:30 p.m. on B1G+. 🆚@USC_Hoops 📍Los Angeles, CA 🕕6:30 p.m. 📺 https://t.co/Wi0aUm9KTS 📊 https://t.co/kAayZZnAsG 🗞️ https://t.co/evr5ONbGFZ
0
6
12
Intersections Magazine is live! Check out all of the great content here with stories on Camille O'Bryant, French Polynesia oceanography, BEACoN research, Goro Kato and more! https://t.co/Hxrf8b40Yu
@CalPoly #calpoly #calpolyproud
0
0
0
0
0
0
New study shows livestreams may improve rattlesnakes’ reputation! Learn more in the story here: https://t.co/SmJmxO5Lei
calpoly.edu
0
2
2
Unlocking the Mysteries of the Universe: Two physics professors are working on some of the biggest questions haunting the universe, thanks to an astronomy research fellowship. https://t.co/PEJtzKzFdR
magazine.calpoly.edu
Two physics professors are working on some of the biggest questions haunting the universe, thanks to an astronomy research fellowship.
0
0
0
Applications for Fall 2026 are now open at all 22 #CalState universities! Complete one application via #CalStateApply and send it to multiple campuses: https://t.co/zpqNJPwreU. 🎒 Opportunities are available for first-year, transfer, graduate, credential, and returning students.
0
3
1
📢 Mustang Athletics News! We have named Carter Henderson our new Director of Athletics, starting Oct. 13! Henderson joins us from @Stanford, bringing 15+ years of leadership in collegiate athletics. 👉 Learn more about his vision for our @CPMustangs
https://t.co/6jJaC0RglR
1
3
25
This week, @CSUdrG met with former CSU Trustee and now Congresswoman @LateefahSimon. From 2016–2024, Rep. Simon was a powerful advocate on the CSU Board of Trustees, where she championed equity and opportunity for all students. Today, we’re grateful to have her voice in the
0
3
6
The newest @CalPoly police officers are now trained to safely handle rattlesnakes that trespass on campus! (They also met Bertha the gopher snake to help them learn how to tell them apart from rattlesnakes.)
1
1
3
New classes, new adventures, same Mustang spirit. 💚💛 From the classroom to the community, Mustangs are ready for another year of learning, leading, and making an impact.
0
3
18